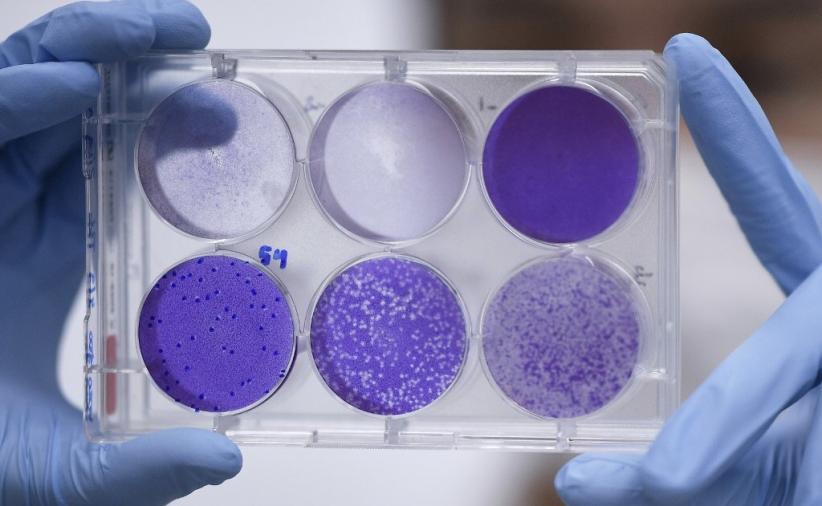
AS Tuduh China Berusaha Curi Data Penelitian Vaksin Virus Corona melalui Hacker

Peneliti Berharap Antibodi Hewan Kerabat Unta Ini Bisa Sembuhkan Corona

BRUSSELS, iNews.id – Antibodi dari llama dikatakan dapat memberikan pertahanan terhadap virus corona (Covid-19) di masa mendatang. Hipotesis tersebut muncul setelah para peneliti menemukan antibodi dari hewan yang masih berkerabat dengan unta itu bisa mencegah virus SARS dan MERS.
Dalam penelitian yang diterbitkan jurnal Cell itu, para periset memfokuskan studi mereka pada antibodi dari seekor llama bernama Winter yang berusia empat tahun. Riset dilakukan di Belgia.
“Bekerja sama dengan rekan-rekan kami di Universitas Ghent di Belgia, kami memvaksinasi llama berusia 4 tahun, bernama Winter, dengan protein dari virus-virus yang menyebabkan wabah MERS dan SARS,” ungkap salah satu peneliti, Daniel Wrapp, kepada Vermont Public Radio awal pekan ini.
“Dari llama, kami dapat mengisolasi dua antibodi yang benar-benar berpotensi menetralkan: satu diarahkan melawan MERS, satu lagi diarahkan melawan SARS, ” tuturnya.
Wrapp mengatakan, timnya yang mulai mempelajari antibodi Winter pada 2016, mencatat hasilnya ketika pandemi global Covid-19 melanda. Para peneliti sekarang sedang mencari cara untuk memulai uji klinis antibodi llama itu.
“Jika uji klinis itu berhasil, Winter layak dibuatkan sebuah monumen untuk mengenang jasanya kelak,” ujar pimpinan dalam penelitian itu kepada New York Times.
Para periset berharap bahwa percobaan mereka pada akhirnya dapat mengarah pada pengobatan untuk membantu melindungi orang-orang yang belum terinfeksi Covid-19, seperti para petugas kesehatan garis depan.
Editor : Ahmad Islamy Jamil